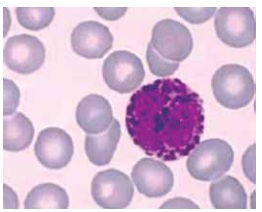
Enunciado 4505922-1

Foram encontradas 970 questões.
Kombu e nori são algas marinhas amplamente utilizadas
na culinária asiática, especialmente na japonesa, tanto
por seu valor nutricional quanto pelo sabor característico
que proporcionam aos pratos. A kombu é uma alga marrom do gênero Laminaria, e a nori é uma alga vermelha
do gênero Porphyra.
Laminaria e Porphyra são
Laminaria e Porphyra são
Provas
Questão presente nas seguintes provas
A figura a seguir ilustra a diversidade de envoltórios
externos de um grupo específico de organismos:
(Disponível em: https://biologo.com.br)
Os organismos que fabricam esses envoltórios são
(Disponível em: https://biologo.com.br)
Os organismos que fabricam esses envoltórios são
Provas
Questão presente nas seguintes provas
Observe a figura a seguir:
(Disponível em: http://berisso.gov.ar)
As bactérias são classificadas, morfologicamente, pelo formato e pela organização colonial.
A imagem apresentada mostra uma micrografia eletrônica de varredura que corresponde a uma colônia bacteriana classificada como
(Disponível em: http://berisso.gov.ar)
As bactérias são classificadas, morfologicamente, pelo formato e pela organização colonial.
A imagem apresentada mostra uma micrografia eletrônica de varredura que corresponde a uma colônia bacteriana classificada como
Provas
Questão presente nas seguintes provas
As bactérias causadoras do tétano, Clostridium tetani, são
organismos que se desenvolvem em ambientes com pouca ou nenhuma presença de oxigênio. Atuam no organismo
liberando uma potente toxina que afeta diretamente o sistema nervoso. As bactérias penetram no organismo, geralmente, por meio de ferimentos profundos.
As bactérias Clostridium tetani
As bactérias Clostridium tetani
Provas
Questão presente nas seguintes provas
A proteína spike é uma estrutura presente no envelope
do coronavírus SARS-CoV-2 que desempenha um papel
essencial na infecção das células-alvo. Ela se liga a um
receptor chamado ACE2, encontrado na superfície de
várias células do corpo, mas principalmente nos pulmões. Essa ligação permite que o vírus entre na célula e
inicie a replicação.
A replicação do coronavírus SARS-CoV-2 se inicia com a adsorção, etapa
A replicação do coronavírus SARS-CoV-2 se inicia com a adsorção, etapa
Provas
Questão presente nas seguintes provas
Leia o excerto a seguir:
O naturalista sueco Carl von Linné (1707-1778), conhecido como Lineu, foi responsável pelo sistema de nomenclatura e de classificação utilizado até hoje para organizar os seres vivos.
O livro Species plantarum, de 1753, no qual Lineu descreveu seu sistema, foi lançado 106 anos antes de Origem das espécies, em que Charles Darwin lançava as bases da teoria da evolução. Para Lineu, ao contrário do que prega o evolucionismo, as espécies eram invariáveis.
(Fábio de Castro, “Pai da taxonomia”. Disponível em: https://agencia.fapesp.br/pai-da-taxonomia/8020. Adaptado)
O primeiro e o segundo parágrafo apresentados citam trabalhos que envolvem conceitos, respectivamente, sobre
O naturalista sueco Carl von Linné (1707-1778), conhecido como Lineu, foi responsável pelo sistema de nomenclatura e de classificação utilizado até hoje para organizar os seres vivos.
O livro Species plantarum, de 1753, no qual Lineu descreveu seu sistema, foi lançado 106 anos antes de Origem das espécies, em que Charles Darwin lançava as bases da teoria da evolução. Para Lineu, ao contrário do que prega o evolucionismo, as espécies eram invariáveis.
(Fábio de Castro, “Pai da taxonomia”. Disponível em: https://agencia.fapesp.br/pai-da-taxonomia/8020. Adaptado)
O primeiro e o segundo parágrafo apresentados citam trabalhos que envolvem conceitos, respectivamente, sobre
Provas
Questão presente nas seguintes provas
A molécula de DNA nos organismos eucariotos se
associa com as moléculas histonas, conforme ilustrado
a seguir:
(Disponível em: www.infoescola.com)
A associação entre as moléculas de DNA e as proteínas histonas
(Disponível em: www.infoescola.com)
A associação entre as moléculas de DNA e as proteínas histonas
Provas
Questão presente nas seguintes provas
A fermentação lática e a fermentação etílica são dois
tipos de processos anaeróbicos. Ambas geram energia para os organismos, embora produzam substâncias
diferentes. Na fermentação lática, o açúcar é transformado em ácido lático; na fermentação etílica, o açúcar é
convertido em etanol e gás carbônico.
Tendo em vista o metabolismo energético das duas fermentações citadas, é correto afirmar que tanto uma molécula de ácido lático como uma molécula de etanol
Tendo em vista o metabolismo energético das duas fermentações citadas, é correto afirmar que tanto uma molécula de ácido lático como uma molécula de etanol
Provas
Questão presente nas seguintes provas
Considere a figura de um basófilo a seguir para responder a questão:
Lâmina de esfregaço sanguíneo – coloração Giemsa.
Aumento total de 1.000 x com óleo de imersão.

(Disponível em: www.unifal-mg.edu.br)
Os basófilos são
Provas
Questão presente nas seguintes provas
Considere a figura de um basófilo a seguir para responder a questão:
Lâmina de esfregaço sanguíneo – coloração Giemsa.
Aumento total de 1.000 x com óleo de imersão.
(Disponível em: www.unifal-mg.edu.br)
Provas
Questão presente nas seguintes provas
Cadernos
Caderno Container